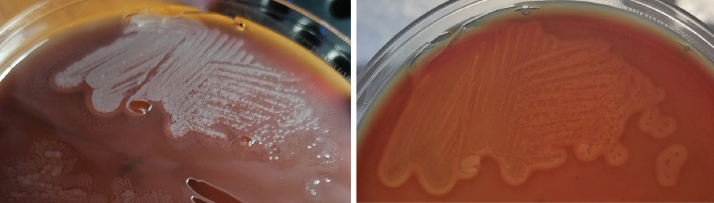
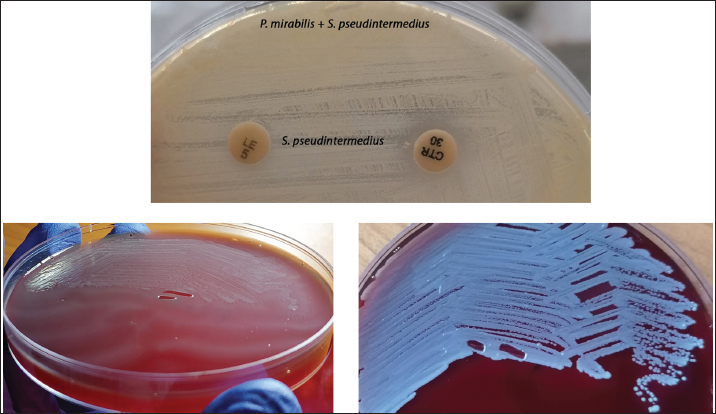

Open Veterinary Journal, (2026), Vol. 16(1): 739-746
Case Report
10.5455/OVJ.2026.v16.i1.70
Microbiological and clinical aspects of complicated canine pyoderma: A case report
Vasil Boyanov1*, Kiril Yordanov Lazov2, Alexandra Alexandrova1, Liliya Yordanova Boyanova1
and Raina Gergova1
1Department of Medical Microbiology, Medical Faculty, Medical University of Sofia, Sofia, Bulgaria
2Duo Vet Veterinary Clinic, Blagoevgrad, Bulgaria
*Corresponding Author: Vasil Boyanov. Department of Medical Microbiology, Faculty of Medicine, Medical University of Sofia, Sofia, Bulgaria. Email: v.boyanov [at] medfac.mu-sofia.bg
Submitted: 09/08/2025 Revised: 11/11/2025 Accepted: 01/12/2025 Published: 31/01/2026
© 2025 Open Veterinary Journal
This is an Open Access article distributed under the terms of the Creative Commons Attribution-Non Commercial-No Derivatives License (http://creativecommons.org/licenses/by-nc-nd/4.0/), which permits non-commercial re-use, distribution, and reproduction in any medium, provided the original work is properly cited, and is not altered, transformed, or built upon in any way.
Abstract
Background: Pyoderma is a common dermatological condition in dogs caused by various bacteria that are typically part of the normal microbiota. Staphylococcus pseudintermedius and Proteus mirabilis are opportunistic pathogens frequently encountered in canines, producing multiple virulence factors with the potential to cause life-threatening infections.
Case Description: We report the case of a 5-year-old dog presented with skin lesions that generalized to a life-threatening condition. The initial treatment with corticosteroids, anti-parasitic medications, and antibiotics was ineffective. Proteus mirabilis was isolated as a sole agent and treated according to the antibiogram with no effect. In subsequent microbiological testing, methicillin-resistant and multidrug-resistant S. pseudintermedius was identified as a coagent using mass spectrometry. The dog died a little over two months after the first symptoms, with clinical signs of septic shock. This case demonstrates the severe complications caused by canine pyoderma and the challenges in the diagnosis and treatment of a mixed enterobacterial/staphylococcal infection. Furthermore, it highlights the significance of evaluating antibiotic susceptibility and the necessity for repeated microbiological sampling when the patient’s condition worsens, despite the results presented.
Conclusion: The empirical administration of corticosteroids and beta-lactams is inappropriate in skin lesions with unclear etiology because corticosteroids may enhance the progression of the infection, whereas beta-lactams are inactive in canine staphylococci in most cases.
Keywords: Dog, Methicillin-resistant Staphylococcus pseudintermedius, Proteus mirabilis, Pyoderma.
Introduction
Canine pyoderma is a common bacterial skin infection encountered in veterinary medicine. It is associated with various predisposing factors related to the structure of the canine epidermis. Furthermore, male gender is considered a risk factor, probably due to a higher rate of superficial injuries (Yılmaz and Baş, 2024; Chan et al., 2025). According to the depth of the process, pyoderma is classified as surface, superficial, and deep, whereas it can be categorized as acute, recurrent, or chronic depending on the course of the infection. Deep pyoderma poses a risk of infection dissemination, with subsequent development of bacteremia and sepsis. Bacteria that are part of the resident microbiota in dogs are typically involved in the etiology (Loeffler and Lloyd, 2018). Staphylococcus spp. are the primary bacterial pathogens associated with this condition; however, gram-negative species such as Proteus spp. contribute to the pathogenesis of infection, especially in cases of deep pyoderma (Hariharan et al., 2014; Parasana et al., 2025).
Staphylococcus pseudintermedius is a member of the Staphylococcus intermedius group (S. intermedius, Staphylococcus delphini, and S. pseudintermedius), which was recognized as a novel species in 2005 (Murugaiyan et al., 2014; Bergot et al., 2018). Staphylococcus pseudintermedius is an opportunist that can be found in the nares, mouth, groin, and perineum of up to 92% of asymptomatic dogs (Roberts et al., 2024). Therefore, S. pseudintermedius is more commonly present in the canine microbiome than S. aureus in humans (Bannoehr and Guardabassi, 2012). It is positive in the free coagulase test, but the clumping factor is generally negative (Bibby and Brown, 2021). Staphylococcus pseudintermedius is the most common cause of pyoderma among companion dogs and cats (İnce and Torun, 2023). Some of its important virulence factors are coagulase, protease, biofilm formation, and the production of numerous toxins, such as leukocidin and phenol-soluble modulins (Maali et al., 2018; Teixeira et al., 2024). The formation of a biofilm makes bacteria 10–100 times more resistant to the action of antibiotics as well as to the factors of the immune system (Silva et al., 2022). The genetic heterogenicity of S. pseudintermedius, its numerous virulence factors, high prevalence among dogs, and its resistance to antimicrobials contribute to its potential to cause severe infections (Paul et al., 2012).
Proteus mirabilis is a gram-negative motile rod that belongs to the Morganellaceae family. The genus was named after a Greek mythological character famous for being able to change shape, while “mirabilis” means wonderful in Latin (Armbruster and Mobley, 2012; Vrioni and Peppas, 2024). Regarding its biochemical properties, it is positive for phenylalanine deaminase, hydrogen sulfide, and urease but negative for indole. The genus Proteus is noteworthy for its swarming growth on solid nutrient media, such as blood agar. This process involves the transition of vegetative rod cells into elongated cells that express thousands of flagella (Armbruster and Mobley, 2012). The high motility of P. mirabilis complicates the isolation of co-agents. Proteus mirabilis has a large number of virulence factors, including flagella, strong urease activity, fimbriae, biofilm production, hemolysins, capsule, proteases, and metallophores, including siderophores (Chakkour et al., 2024). It is a part of the gastrointestinal tract microbiota in both animals and humans, and it can be found in soil and sewage (Armbruster et al., 2018). According to a study, 27.9 % of companion dogs and 36.2% of stray dogs had the species in fecal samples (Liu et al., 2023). Proteus mirabilis causes urinary tract infections, otitis externa, and occasionally pyoderma in dogs (Sinnott-Stutzman and Sykes, 2021).
The complex polymicrobial nature of canine pyoderma can affect treatment approaches. In cases of coinfection, microbiological diagnosis, antimicrobial susceptibility testing, and treatment are difficult (Lynch and Helbig, 2021; Chan et al., 2025).
Case Details
The patient is a 5-year-old male companion English Bulldock that weighs 21 kg. Anamnesis of initial symptoms and treatment was obtained from owners’ data and accompanying medical documentation. The first symptoms appeared in July 2024, presenting red nonsecreting and nonitching lesions in the folds of the back. The dog was administered a corticosteroid shot and treated against ectoparasites with fipronil. The therapy had not taken effect, and the condition worsened a week later. The skin lesions had expanded, involving the extremities. Dexamethasone (0.2 mg/kg/daily, i.m.) and empirical antibiotic treatment with benzylpenicillin (1 ml/10 kg, s.c.) were prescribed for 10 days. The antibiotic treatment was continued with amoxicillin/clavulanic acid tablets (125 mg, twice daily) and oral prednisolone for an additional 10 days. The patient’s condition had not improved (Fig. 1). A microbiological sample was collected that showed P. mirabilis as the only isolate. The pathological examination provided histological proof of pyoderma, thus validating the clinical findings of this dermatological condition.

Fig. 1. Clinical timeline presenting information in a chronological order, highlighting the important dates, procedures, and outcomes related to the reported case.
The first visit to our clinic was 2 months after the initial symptoms (September, 2024) when the dog presented with deep pyoderma with multiple furuncles and pyo-hemorrhagic ulcers (Fig. 2). The complete blood count revealed leukocytosis 33.109/l [reference value (RV) up to 17.109/l), neutrophilia 25.109/l (RV up to 13.109/l), mild microcytic anemia with red blood cells 4,1.1012 (RV higher than 5.1012), and MCV at 45 fl (RV higher than 60 fl). The biochemical blood tests showed elevated creatine phosphokinase 558 U/l (RV up to 440 U/l) and alkaline phosphatase 338 (RV up to 300 U/l), while liver transaminases, urea, and creatinine were within the reference ranges. Hypothyroidism, a possible reason for pyoderma, was excluded by TSH and T4 testing. Treatment was continued with amikacin (20 mg/kg/day, intravenously) according to the antibiogram. Unfortunately, no improvement in the clinical condition was observed. Therefore, three days later, the owners of the dog refused further manipulations and treatment. Meanwhile, a second microbiological culture was collected and delivered to our diagnostic laboratory in transport nutrient medium.

Fig. 2. The dog with clinical symptoms of deep pyoderma. Scale bar=5 cm
Blood agar, MacConkey agar, Sabouraud medium, and thioglycolate broth were inoculated. We made a glass slide on which we observed gram-negative rods and gram-positive cocci. The nutrient media results were as follows: massive growth of a gram-positive beta-hemolytic bacterium on blood agar in the presence of Proteus sp., massive growth of lactose-negative colonies on McConkey agar, and no growth on Sabouraud. The swarming growth of Proteus sp. made it difficult to isolate pure cultures of the other species (Fig. 3). We unsuccessfully tried to inhibit the motility of Proteus sp. by a method described by French authors, dropping 90% ethanol on the lid of the petri dish (Hernandez et al., 1999). Thereafter, we made a mixed antibiogram on Muller-Hinton agar using a suspension containing both agents. Subsequently, we could isolate the gram-positive species because only it provided growth next to the levofloxacin and ceftriaxone discs (Fig. 4). Further tests were performed. Some conventional methods used in the diagnostics of gram-positive and gram-negative bacteria, such as the catalase test, clumping factor test, and tube coagulase test, as well as Kligler’s iron agar, indole test, and urease tests, were applied. The gram-positive specimen was misdiagnosed as S. epidermidis with a probability of 92% by BD Phoenix™ M50 (Becton Dickinson, New Jersey, USA). The final identification of both species was performed using MALDI-TOF MS (VITEK MS system, bioMerieux, Craponne, France). Proteus mirabilis and S. pseudintermedius. Bauer-Kirby disc diffusion method was used to determine antimicrobial susceptibility. The interpretation was done according to the European Union for the Conservation of Species and Antibiotics (EUCAST) guidelines (2024) (EUCAST, 2024). S. pseudintermedius was multidrug-resistant (MDR), including methicillin resistant. The results are presented in Table 1.
Fig. 3. Mixed cultures of the tested pathogens. Proteus exhibited swarming growth on solid nutrient media, whereas the second isolate exhibited beta-hemolysis.
Fig. 4. Mixed antibiogram with only the second isolate exhibiting growth adjacent to the levofloxacin and ceftriaxone discs, allowing its isolation in pure culture. Pure cultures of both pathogens (P. mirabilis and S. pseudintermedius) are also presented.
Table 1. Antimicrobial susceptibility of P. mirabilis and S. pseudintermedius.

The dog died at home three days after treatment discontinuation. The patient’s condition severely deteriorated in the last 24 hours before death. The antemortem symptoms were typical of septic shock: refusal of food and water, adynamia, shivering, and hypothermia (36°C). The owners of the dog declined additional laboratory examinations to validate the clinical observations of septic shock and subsequently refused an autopsy.
Ethical approval
Informed consent and consent for the publication of statements were obtained from the dog owner.
Discussion
Staphylococcus pseudintermedius is the most commonly isolated pathogen in canine skin infections and otitis externa (Priyantha, 2020). According to a recent meta-analysis, S. pseudintermedius was detected in 78.9% of the samples, whereas P. mirabilis was detected in 16.3% (Tanveer et al., 2024). In a study from South Africa (Prior et al., 2022), it was detected in 83.8% of the samples. The majority of them (85.9%) were methicillin-resistant (Prior et al., 2022). We found a case report of canine pyoderma caused by S. pseudintermedius and P. mirabilis with competitive resolution in the literature. Notably, the diagnosis was superficial pyoredma, not deep pyoderma (Jeong and Oh, 2011). In another case report, P. mirabilis caused deep sheep pyoderma at an injection site. The treatment was again successful (Abdollahi et al., 2022). In a study conducted in Hong Kong that involved 63 clinical isolates of canine pyoderma, S. pseudintermedius emerged as the most prevalent species. Furthermore, Proteus spp. were detected in 8.2% of the samples, suggesting that they are significant pathogens associated with pyoderma (Chan et al., 2025). In accordance with the reported cases, there were challenges in both microbiological diagnostics and treatment, highlighting the importance of coinfections and the need for testing antibiotic susceptibility.
The empiric treatment of canine pyoderma with beta-lactams is inappropriate because of the high prevalence of methicillin-resistant staphylococci among dogs (Prior et al., 2022). Collecting microbiological samples before starting antibiotic treatment is always recommended. However, in the initial stages of pyoderma, the relationship between colonizing and causative agents can be ambiguous (Doelle et al., 2016). The subsequent treatment with amikacin, although based on the antibiogram, did not take effect because the staphylococcal species was simultaneously methicillin- and aminoglycoside-resistant. According to a study, 37.0% of methicillin-resistant S. pseudintermedius are amikacin-resistant (Bhooshan et al., 2020). The use of beta-lactams and aminoglycosides probably enhanced the growth of S. pseudintermedius. S. pseudintermedius was not reported in the first microbiological result, and its antibiogram was obtained post-mortem. According to the final results, vancomycin would have been an appropriate treatment for bacteriemia caused by S. pseudintermedius. However, the current EU regulations state that the administration of vancomycin is prohibited in veterinary medicine (Commission Implementing Regulation EU 2022/1255, 2022).
Some authors (Coyner, 2012) do not recommend the prolonged use of injectable corticosteroids in pyoderma because they lower the immune defense that can cause deep pyoderma progression. Low-dose corticosteroid administration is appropriate in cases of itching pyoderma (Coyner, 2012). It is justified to prevent auto contamination. In this case, the dog had no pruritus symptoms.
Identification of S. pseudintermedius is challenging and time-consuming. On the one hand, it can be mistaken for S. aureus because of the beta-hemolysis and positive coagulase test results. However, it can be confused with coagulase-negative staphylococcal species because of the negative clumping factor test. Erroneous diagnosis can also occur within the S. intermedius group. While most of the diagnostic procedures used in the identification of human pathogens are not sufficiently accurate in the diagnostics of animal isolates, MALDI-TOF MS is a reliable method for veterinary agents, including those within the S. intermedius group. Furthermore, multiplex polymerase chain reaction for the identification of pathogens, along with DNA sequencing, represents another approach for providing a definitive diagnosis (Verstappen et al., 2017; Loeffler and Lloyd, 2018). However, the equipment for the aforementioned methods is expensive and still not available in many diagnostic laboratories. Notably, all the methods for identification, including MALDI-TOF MS, require an isolated pure culture of the agent, which is a multi-step process in the presence of Proteus sp.
The increasing rate of methicillin-resistant canine staphylococci, such as S. pseudintermedius, S. aureus, and Staphylococcus schleiferi is concerning. S. pseudintermedius is the most significant causative agent in dogs. The majority of the methicillin-resistant S. pseudintermedius are also MDR (Sobkowich et al., 2025). This raises the question about the imprudent use of antibiotics in veterinary medicine and in agriculture, which leads to the selection of resistant strains for both animals and humans. Additionally, methicillin-resistant S. pseudintermedius can be spread from animal to human through close contact or biting, causing soft tissue and wound infections. Immunocompromised individuals are at an extreme risk of severe life-threatening complications (Moses et al., 2023). The beta-lactam class is the most commonly used class in veterinary medicine, particularly for the treatment of small animals, and it has been recognized as a major contributor to the spread of MRSP (Nocera and De Martino, 2024). Guidelines for the treatment of MRSP in veterinary medicine must be created and strictly followed. Furthermore, non-antibiotic agents with known anti-staphylococcal activity, such as DIBI, manuka, and silver nanoparticles, should be further investigated and possibly implemented in veterinary practice (Nocera and De Martino, 2024). In addition, some precautions should be observed when caring for dogs, such as regular bathing, cleaning of the ears, cleaning of the living area, isolation of already infected animals, balanced diet, and regular preventive examinations. Regarding dog owners, proper handwashing after contact with a pet must be done (Sudha, 2025).
The presented data support our findings regarding the significance of coinfections in canine pyoderma and the emergence of MDR pathogens, which pose difficulties in both diagnosis and treatment. The timely identification of all causative agents and the determination of antimicrobial susceptibility are crucial for the outcome of this study.
Conclusion
Bacterial resistance is a significant challenge in modern veterinary medicine. Determining the appropriate antibiotic therapy can be challenging when MDR pathogens are involved. The empirical use of corticosteroids and beta-lactams is unsuitable for skin lesions with an uncertain cause, as corticosteroids can exacerbate the infection’s progression, whereas beta-lactams are generally inactive in cases of canine staphylococci.
Acknowledgments
We thank the dog owners for their assistance in providing the data necessary for this study.
Conflict of interest
The authors have no conflicts of interest to declare.
Funding
None
Authors’ contributions
All authors listed have made a substantial, direct, and intellectual contribution to the work and have approved it for publication.
Data availability
All datasets generated or analyzed during the study are included in the revised manuscript.
References
Abdollahi, M., Javan, A.J., Shokrpoor, S., Beidokhtinezhad, M. and Tamai, I.A. 2022. Pyoderma caused by Proteus mirabilis in sheep. Vet. Med. Sci. 8, 2562–2567; doi:10.1002/vms3.926
Armbruster, C.E. and Mobley, H.L.T. 2012. Merging mythology and morphology: the multifaceted lifestyle of Proteus mirabilis. Nat. Rev. Microbiol. 10, 743–754; doi:10.1038/nrmicro2890
Armbruster, C.E., Mobley, H.L.T. and Pearson, M.M. 2018. Pathogenesis of Proteus mirabilis infection. EcoSal. Plus. 8(10), doi:10.1128/ecosalplus.esp-0009-2017
Bannoehr, J. and Guardabassi, L. 2012. Staphylococcus pseudintermedius in the dog: taxonomy, diagnostics, ecology, epidemiology and pathogenicity. Vet. Dermatol. 23, 253–266; doi:10.1111/j.1365-3164.2012.01046.x
Bergot, M., Martins-Simoes, P., Kilian, H., Châtre, P., Worthing, K.A., Norris, J.M., Madec, J.Y., Laurent, F. and Haenni, M. 2018. Evolution of the population structure of Staphylococcus pseudintermedius in France. Front. Microbiol. 9, 3055; doi:10.3389/fmicb.2018.03055
Bhooshan, S., Negi, V. and Khatri, P.K. 2020. Staphylococcus pseudintermedius: an undocumented, emerging pathogen in humans. GMS. Hyg. Infect. Control 15, 32; doi:10.3205/dgkh000367
Bibby, H.L. and Brown, K.L. 2021. Identification of Staphylococcus pseudintermedius isolates from wound cultures by matrix-assisted laser desorption ionization– time of flight mass spectrometry improves accuracy of susceptibility reporting at an increase in cost. J. Clin. Microbiol. 59, 973.
Chakkour, M., Hammoud, Z., Farhat, S., El Roz, A., Ezzeddine, Z. and Ghssein, G. 2024. Overview of Proteus mirabilis pathogenicity and virulence. Insights into the role of metals. Front. Microbiol. 15, 1383618; doi:10.3389/fmicb.2024.1383618
Chan, W.Y., Hobi, S., Ferguson, A. and Elsohaby, I. 2025. Canine pyoderma and otitis externa: a retrospective analysis of multidrug-resistant bacterial carriage in Hong Kong. Antibiotics 14, 685; doi:10.3390/antibiotics14070685
Commission Implementing Regulation (EU) 2022/1255 designating antimicrobials or groups of antimicrobials reserved for treatment of certain infections in humans, in accordance with Regulation (EU) 2019/6 of the European Parliament and of the Council; European Commission: Brussels, Belgium (2022); Available via https://eur lex.europa.eu/legal-content/EN/TXT/PDF/?uri=CELEX:320 22R1255 (Accessed 10 October, 2025).
Coyner, K.S. 2012. Challenges and new developments in canine pyoderma: topical and systemic treatment. TVP 3, 38–44.
Doelle, M., Loeffler, A., Wolf, K., Kostka, V. and Linek, M. 2016. Clinical features, cytology and bacterial culture results in dogs with and without cheilitis and comparison of three sampling techniques. Vet. Dermatol. 27, 140–e37; doi:10.1111/vde.12300
Hariharan, H., Gibson, K., Peterson, R., Frankie, M., Matthew, V., Daniels, J., Martin, N.A., Andrews, L., Paterson, T. and Sharma, R.N. 2014. Staphylococcus pseudintermedius and Staphylococcus schleiferi subspecies coagulans from canine pyoderma cases in Grenada, West Indies, and their susceptibility to beta-lactam drugs. Vet. Med. Int. 2014, 850126; doi:10.1155/2014/850126
Hernandez, E., Ramisse, F. and Cavallo, J.D. 1999. Abolition of swarming of Proteus. J. Clin. Microbiol. 37, 3435.
İnce, S.S. and Torun, E. 2023. Detection of bacterial and fungal agents in the skin of various domestic animals. J. Etlik Vet. Microbiol. 34, 139–145; doi:10.35864/evmd.1273578
Jeong, H.H. and Oh, T.H. 2011. Recurrent superficial pyoderma caused by mixed infection of Proteus mirabilis and Staphylococcus pseudointermedius in a Yorkshire Terrier dog. J. Vet. Clin. 28, 538–541.
Liu, L., Dong, Z., Ai, S., Chen, S., Dong, M., Li, Q., Zhou, Z., Liu, H., Zhong, Z., Ma, X., Hu, Y., Ren, Z., Fu, H., Shu, G., Qiu, X. and Peng, G. 2023. Virulence-related factors and antimicrobial resistance in Proteus mirabilis isolated from domestic and stray dogs. Front. Microbiol. 14, 1141418; doi:10.3389/fmicb.2023.1141418
Loeffler, A. and Lloyd, D.H. 2018. What has changed in canine pyoderma? A narrative review. Vet. J. 235, 73–82; doi:10.1016/j.tvjl.2018.04.002
Lynch, S.A. and Helbig, K.J. 2021. The Complex Diseases of Staphylococcus pseudintermedius in Canines: where to Next?. Vet. Sci. 8, 11; doi:10.3390/vetsci8010011
Maali, Y., Badiou, C., Martins-Simões, P., Hodille, E., Bes, M., Vandenesch, F., Lina, G., Diot, A., Laurent, F. and Trouillet-Assant, S. 2018. Understanding the virulence of Staphylococcus pseudintermedius: a major role of pore-forming toxins. Front. Cell. Infect. Microbiol. 8, 221; doi:10.3389/fcimb.2018.00221
Moses, I.B., Santos, F.F. and Gales, A.C. 2023. Human colonization and infection by Staphylococcus pseudintermedius: an emerging and underestimated zoonotic pathogen. Microorganisms 11, 581; doi:10.3390/microorganisms11030581
Murugaiyan, J., Walther, B., Stamm, I., Abou-Elnaga, Y., Brueggemann-Schwarze, S., Vincze, S., Wieler, L.H., Lübke-Becker, A., Semmler, T. and Roesler, U. 2014. Species differentiation within the Staphylococcus intermedius group using a refined MALDI-TOF MS database. Clin. Microbiol. Infect. 20, 1007–1015; doi:10.1111/1469-0691.12662
Nocera, F.P. and De Martino, L. 2024. Methicillin-resistant Staphylococcus pseudintermedius: epidemiological changes, antibiotic resistance, and alternative therapeutic strategies. Vet. Res. Commun. 48, 3505–3515; doi:10.1007/s11259-024-10508-8
Parasana, D.K., Kalyani, I.H., Kachchhi, A.V., Koringa, P.G., Makwana, P.M., Patel, D.R., Ramani, U.V., Javia, B.B. and Ghodasara, S.N. 2025. Profiling of antimicrobial resistance genes from Staphylococcus pseudintermedius isolated from dogs with pyoderma using whole genome sequencing. Comparative Immunol. Microbiol. Infect. Dis. 116, 102288; doi:10.1016/j.cimid.2024.102288
Paul, N.C., Bärgman, S.C., Moodley, A., Nielsen, S.S. and Guardabassi, L. 2012. Staphylococcus pseudintermedius colonization patterns and strain diversity in healthy dogs: a cross-sectional and longitudinal study. Vet. Microbiol. 160, 420–427.
Prior, C.D., Moodley, A., Karama, M., Malahlela, M.N. and Leisewitz, A. 2022. Prevalence of methicillin resistance in Staphylococcus pseudintermedius isolates from dogs with skin and ear infections in South Africa. J. S. Afr. Vet. Assoc. 93, 40a–40h.
Priyantha, M. 2020. Review of Staphylococcus pseudintermedius infection in dogs and humans. Sri Lanka Vet. J. 67, 1–9; doi: 10.4038/slvj.v67i1-2.51
Roberts, E., Nuttall, T.J., Gkekas, G., Mellanby, R.J., Fitzgerald, J.R. and Paterson, G.K. 2024. Not just in man’s best friend: a review of Staphylococcus pseudintermedius host range and human zoonosis. Res. Vet. Sci. 174, 105305; doi:10.1016/j.rvsc.2024.105305
Silva, V., Correia, E., Pereira, J.E., González-Machado, C., Capita, R., Alonso-Calleja, C., Igrejas, G. and Poeta, P. 2022. Exploring the biofilm formation capacity in S. pseudintermedius and coagulase-negative staphylococci species. Pathogens 11, 689; doi:10.3390/pathogens11060689
Sinnott-Stutzman, V. and Sykes, J. 2021. Gram-Negative bacterial infections. In Greene’s infectious diseases of the dog and cat, 5th ed.. Ed., Sykes, J.E. Philadelphia, PA: Elsevier Sauders, pp: 643–654.
Sobkowich, K.E., Hui, A.Y., Poljak, Z., Szlosek, D., Plum, A. and Weese, J.S. 2025. Nationwide analysis of methicillin-resistant staphylococci in cats and dogs: resistance patterns and geographic distribution. Am. J. Vet. Res. 86, ajvr.24.09.0253; doi:10.2460/ajvr.24.09.0253
Sudha, A.K. 2025. A review on Staphylococcus pseudintermedius. Int. J. Sci. Res. Manag. 13, 1335–1339; doi:10.18535/ijsrm/v13i02.mp04
Tanveer, M., Ntakiyisumba, E., Hirwa, F., Yoon, H., Oh, S.I., Kim, C., Kim, M.H., Yoon, J.S. and Won, G. 2024. Prevalence of bacterial pathogens isolated from canines with pyoderma and otitis externa in Korea: a systematic review and meta-analysis. Vet. Sci. 11, 656; doi:10.3390/vetsci11120656
Teixeira, I.M., De Moraes Assumpção, Y., Paletta, A.C.C., Antunes, M., Da Silva, I.T., Jaeger, L.H., Ferreira, R.F., De Oliveira Ferreira, E. and De Araújo Penna, B. 2024. Investigation on biofilm composition and virulence traits of S. pseudintermedius isolated from infected and colonized dogs. Braz. J. Microbiol. 55, 2923–2936; doi:10.1007/s42770-024-01405-y
EUCAST. 2024. Breakpoint tables for interpretation of MICs and zone diameters. Version 14.0. Basel, Switzerland: The European Committee on Antimicrobial Susceptibility Testing; 2024 (Accessed 15 September 2024)
Verstappen, K.M., Huijbregts, L., Spaninks, M., Wagenaar, J.A., Fluit, A.C. and Duim, B. 2017. Development of a real-time PCR for detection of Staphylococcus pseudintermedius using a novel automated comparison of whole-genome sequences. PLos One. 12, 183925; doi:10.1371/journal.pone.0183925
Vrioni, G. and Peppas, T.A. 2024. What’s in a name? Hellenic origins of microbiological nomenclature. Acta. Microbiol. Hell. 69, 93–100; doi:10.3390/amh69020010
Yılmaz, N.K. and Baş, B. 2024. Superficial pyoderma in cats and dogs: a retrospective clinical study. Ankara. Univ. Vet. Fak. Derg. 71, 207–213.